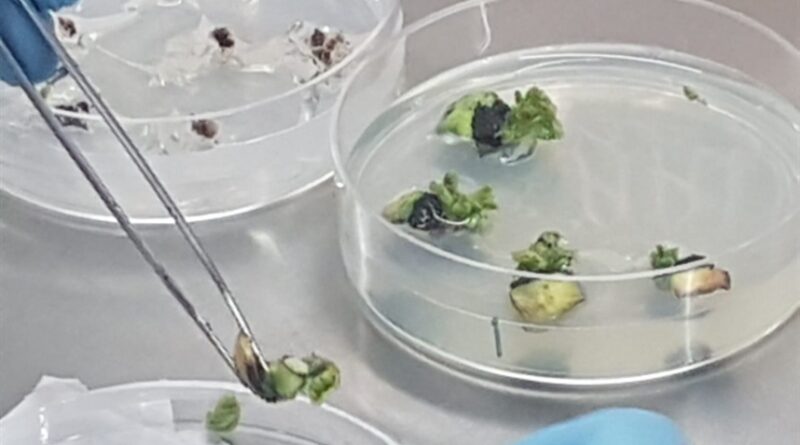

Teste auxilia na seleção de sementes mais vigorosas
O teste possibilita prever como as sementes irão se comportar ao longo do tempo
Agrolink
– Leonardo Gottems

O teste possibilita prever como as sementes irão se comportar ao longo do tempo – Foto: Divulgação
De acordo com Raíner Kesley, Analista de Qualidade de Sementes da Sementes Jotabasso, o Teste de Envelhecimento Acerado (E.A) é uma das principais ferramentas utilizadas no Controle de Qualidade para identificar lotes de sementes com maior potencial fisiológico. O procedimento simula condições extremas de temperatura e umidade, acelerando o processo de envelhecimento das sementes e revelando sua real capacidade de germinação e vigor.
Entre os principais benefícios do teste está a predição do desempenho em campo, pois ele permite identificar quais lotes têm maior capacidade de germinar e se estabelecer em ambientes adversos. Isso contribui diretamente para a tomada de decisão técnica, facilitando a escolha dos lotes mais adequados para plantios mais exigentes e garantindo maior segurança ao agricultor.
Outro ponto destacado por Raíner é a avaliação da qualidade no armazenamento. O teste possibilita prever como as sementes irão se comportar ao longo do tempo até serem entregues ao produtor final, o que é fundamental para manter a integridade do material durante a estocagem. Além disso, o E.A proporciona mais assertividade no processo, ao detectar possíveis falhas que poderiam comprometer a emergência das plantas, reduzindo perdas no campo.
Dessa forma, o Teste de Envelhecimento Acerado se mostra indispensável na seleção de sementes mais vigorosas, elevando a qualidade dos lotes disponibilizados ao mercado e contribuindo diretamente para o sucesso das lavouras. As informações foram divulgadas no perfil oficial de Kesley na rede social LinkedIn.